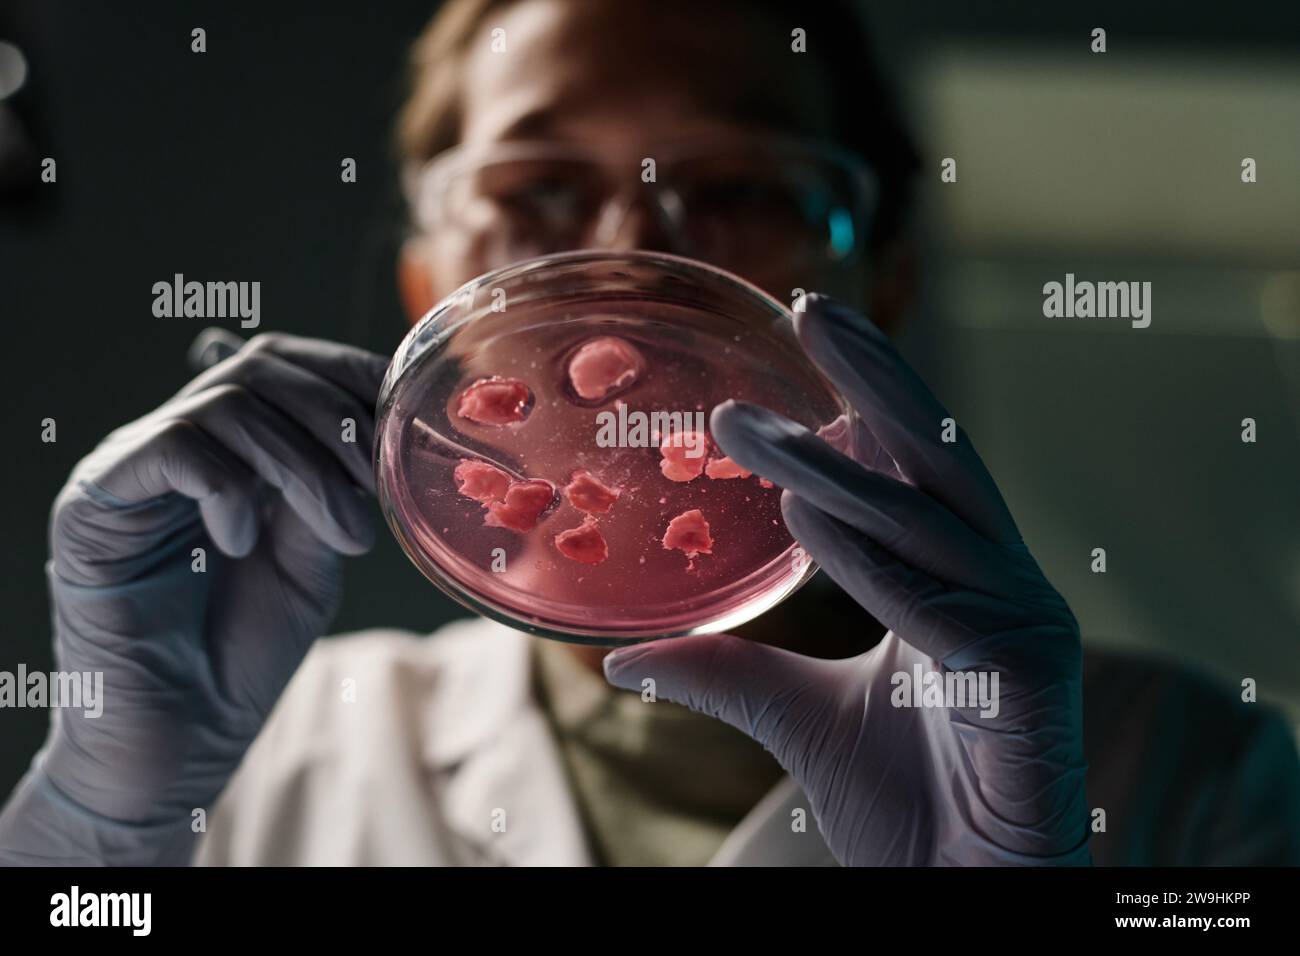

Stockfotos & Bilder
(35,922)Stockfotos & Bilder
 Gruppe der Politik sitzt auf der Militärkonferenz und spricht mit Journalisten Stockfotohttps://www.alamy.de/image-license-details/?v=1https://www.alamy.de/gruppe-der-politik-sitzt-auf-der-militarkonferenz-und-spricht-mit-journalisten-image576290712.html
Gruppe der Politik sitzt auf der Militärkonferenz und spricht mit Journalisten Stockfotohttps://www.alamy.de/image-license-details/?v=1https://www.alamy.de/gruppe-der-politik-sitzt-auf-der-militarkonferenz-und-spricht-mit-journalisten-image576290712.htmlRF2TDG8K4–Gruppe der Politik sitzt auf der Militärkonferenz und spricht mit Journalisten
 Politiker diskutieren gemeinsam auf einer Militärkonferenz über die Konfliktlösung Stockfotohttps://www.alamy.de/image-license-details/?v=1https://www.alamy.de/politiker-diskutieren-gemeinsam-auf-einer-militarkonferenz-uber-die-konfliktlosung-image576291568.html
Politiker diskutieren gemeinsam auf einer Militärkonferenz über die Konfliktlösung Stockfotohttps://www.alamy.de/image-license-details/?v=1https://www.alamy.de/politiker-diskutieren-gemeinsam-auf-einer-militarkonferenz-uber-die-konfliktlosung-image576291568.htmlRF2TDG9NM–Politiker diskutieren gemeinsam auf einer Militärkonferenz über die Konfliktlösung
 Gruppe von Politikern, die in Mikrofonen sprechen und Journalisten auf der Militärkonferenz ein Interview geben Stockfotohttps://www.alamy.de/image-license-details/?v=1https://www.alamy.de/gruppe-von-politikern-die-in-mikrofonen-sprechen-und-journalisten-auf-der-militarkonferenz-ein-interview-geben-image576291131.html
Gruppe von Politikern, die in Mikrofonen sprechen und Journalisten auf der Militärkonferenz ein Interview geben Stockfotohttps://www.alamy.de/image-license-details/?v=1https://www.alamy.de/gruppe-von-politikern-die-in-mikrofonen-sprechen-und-journalisten-auf-der-militarkonferenz-ein-interview-geben-image576291131.htmlRF2TDG963–Gruppe von Politikern, die in Mikrofonen sprechen und Journalisten auf der Militärkonferenz ein Interview geben
 Arbeitsplatz mit Glaswaren und professioneller technischer Ausrüstung im wissenschaftlichen Labor Stockfotohttps://www.alamy.de/image-license-details/?v=1https://www.alamy.de/arbeitsplatz-mit-glaswaren-und-professioneller-technischer-ausrustung-im-wissenschaftlichen-labor-image591072919.html
Arbeitsplatz mit Glaswaren und professioneller technischer Ausrüstung im wissenschaftlichen Labor Stockfotohttps://www.alamy.de/image-license-details/?v=1https://www.alamy.de/arbeitsplatz-mit-glaswaren-und-professioneller-technischer-ausrustung-im-wissenschaftlichen-labor-image591072919.htmlRF2W9HKF3–Arbeitsplatz mit Glaswaren und professioneller technischer Ausrüstung im wissenschaftlichen Labor
 Unerkennbare Wissenschaftlerin bei der Analyse verschiedener Rohfleischsorten im Labor Stockfotohttps://www.alamy.de/image-license-details/?v=1https://www.alamy.de/unerkennbare-wissenschaftlerin-bei-der-analyse-verschiedener-rohfleischsorten-im-labor-image591073043.html
Unerkennbare Wissenschaftlerin bei der Analyse verschiedener Rohfleischsorten im Labor Stockfotohttps://www.alamy.de/image-license-details/?v=1https://www.alamy.de/unerkennbare-wissenschaftlerin-bei-der-analyse-verschiedener-rohfleischsorten-im-labor-image591073043.htmlRF2W9HKKF–Unerkennbare Wissenschaftlerin bei der Analyse verschiedener Rohfleischsorten im Labor
 Nahaufnahme einer Petrischale mit Pflanzenprobe in Handschuhhänden des Wissenschaftlers Stockfotohttps://www.alamy.de/image-license-details/?v=1https://www.alamy.de/nahaufnahme-einer-petrischale-mit-pflanzenprobe-in-handschuhhanden-des-wissenschaftlers-image591073804.html
Nahaufnahme einer Petrischale mit Pflanzenprobe in Handschuhhänden des Wissenschaftlers Stockfotohttps://www.alamy.de/image-license-details/?v=1https://www.alamy.de/nahaufnahme-einer-petrischale-mit-pflanzenprobe-in-handschuhhanden-des-wissenschaftlers-image591073804.htmlRF2W9HMJM–Nahaufnahme einer Petrischale mit Pflanzenprobe in Handschuhhänden des Wissenschaftlers
 Junge Forscher, die am Schreibtisch im Labor sitzen und kleine Kräuterproben mit einer Zange in Petrischale geben Stockfotohttps://www.alamy.de/image-license-details/?v=1https://www.alamy.de/junge-forscher-die-am-schreibtisch-im-labor-sitzen-und-kleine-krauterproben-mit-einer-zange-in-petrischale-geben-image591073673.html
Junge Forscher, die am Schreibtisch im Labor sitzen und kleine Kräuterproben mit einer Zange in Petrischale geben Stockfotohttps://www.alamy.de/image-license-details/?v=1https://www.alamy.de/junge-forscher-die-am-schreibtisch-im-labor-sitzen-und-kleine-krauterproben-mit-einer-zange-in-petrischale-geben-image591073673.htmlRF2W9HME1–Junge Forscher, die am Schreibtisch im Labor sitzen und kleine Kräuterproben mit einer Zange in Petrischale geben
 afroamerikanischer Wissenschaftler sitzt am Arbeitsplatz im Labor und arbeitet mit Mikroskop Stockfotohttps://www.alamy.de/image-license-details/?v=1https://www.alamy.de/afroamerikanischer-wissenschaftler-sitzt-am-arbeitsplatz-im-labor-und-arbeitet-mit-mikroskop-image591073327.html
afroamerikanischer Wissenschaftler sitzt am Arbeitsplatz im Labor und arbeitet mit Mikroskop Stockfotohttps://www.alamy.de/image-license-details/?v=1https://www.alamy.de/afroamerikanischer-wissenschaftler-sitzt-am-arbeitsplatz-im-labor-und-arbeitet-mit-mikroskop-image591073327.htmlRF2W9HM1K–afroamerikanischer Wissenschaftler sitzt am Arbeitsplatz im Labor und arbeitet mit Mikroskop
 Mittlere Aufnahme einer asiatischen Laborarbeiterin, die mit Ausrüstung an ihrem Schreibtisch sitzt und in die Kamera schaut Stockfotohttps://www.alamy.de/image-license-details/?v=1https://www.alamy.de/mittlere-aufnahme-einer-asiatischen-laborarbeiterin-die-mit-ausrustung-an-ihrem-schreibtisch-sitzt-und-in-die-kamera-schaut-image591073497.html
Mittlere Aufnahme einer asiatischen Laborarbeiterin, die mit Ausrüstung an ihrem Schreibtisch sitzt und in die Kamera schaut Stockfotohttps://www.alamy.de/image-license-details/?v=1https://www.alamy.de/mittlere-aufnahme-einer-asiatischen-laborarbeiterin-die-mit-ausrustung-an-ihrem-schreibtisch-sitzt-und-in-die-kamera-schaut-image591073497.htmlRF2W9HM7N–Mittlere Aufnahme einer asiatischen Laborarbeiterin, die mit Ausrüstung an ihrem Schreibtisch sitzt und in die Kamera schaut
Tiefwinkelnaht einer Petrischale mit Fleischstücken in den Händen einer jungen Wissenschaftlerin, die sie untersucht Stockfotohttps://www.alamy.de/image-license-details/?v=1https://www.alamy.de/tiefwinkelnaht-einer-petrischale-mit-fleischstucken-in-den-handen-einer-jungen-wissenschaftlerin-die-sie-untersucht-image591073134.html
Tiefwinkelnaht einer Petrischale mit Fleischstücken in den Händen einer jungen Wissenschaftlerin, die sie untersucht Stockfotohttps://www.alamy.de/image-license-details/?v=1https://www.alamy.de/tiefwinkelnaht-einer-petrischale-mit-fleischstucken-in-den-handen-einer-jungen-wissenschaftlerin-die-sie-untersucht-image591073134.htmlRF2W9HKPP–Tiefwinkelnaht einer Petrischale mit Fleischstücken in den Händen einer jungen Wissenschaftlerin, die sie untersucht
 Junger asiatischer Forscher, der während der Arbeit im Labor die Partikel von rohem Fleisch aufmerksam untersucht Stockfotohttps://www.alamy.de/image-license-details/?v=1https://www.alamy.de/junger-asiatischer-forscher-der-wahrend-der-arbeit-im-labor-die-partikel-von-rohem-fleisch-aufmerksam-untersucht-image591073124.html
Junger asiatischer Forscher, der während der Arbeit im Labor die Partikel von rohem Fleisch aufmerksam untersucht Stockfotohttps://www.alamy.de/image-license-details/?v=1https://www.alamy.de/junger-asiatischer-forscher-der-wahrend-der-arbeit-im-labor-die-partikel-von-rohem-fleisch-aufmerksam-untersucht-image591073124.htmlRF2W9HKPC–Junger asiatischer Forscher, der während der Arbeit im Labor die Partikel von rohem Fleisch aufmerksam untersucht
 Zwei Wissenschaftler analysierten Hamburger mit Fleisch aus Labor, eine Forscherin macht Notizen auf Tablette Stockfotohttps://www.alamy.de/image-license-details/?v=1https://www.alamy.de/zwei-wissenschaftler-analysierten-hamburger-mit-fleisch-aus-labor-eine-forscherin-macht-notizen-auf-tablette-image591073290.html
Zwei Wissenschaftler analysierten Hamburger mit Fleisch aus Labor, eine Forscherin macht Notizen auf Tablette Stockfotohttps://www.alamy.de/image-license-details/?v=1https://www.alamy.de/zwei-wissenschaftler-analysierten-hamburger-mit-fleisch-aus-labor-eine-forscherin-macht-notizen-auf-tablette-image591073290.htmlRF2W9HM0A–Zwei Wissenschaftler analysierten Hamburger mit Fleisch aus Labor, eine Forscherin macht Notizen auf Tablette
 Professioneller afroamerikanischer Forscher, der künstliches Fleisch durch das Mikroskop betrachtet Stockfotohttps://www.alamy.de/image-license-details/?v=1https://www.alamy.de/professioneller-afroamerikanischer-forscher-der-kunstliches-fleisch-durch-das-mikroskop-betrachtet-image591073288.html
Professioneller afroamerikanischer Forscher, der künstliches Fleisch durch das Mikroskop betrachtet Stockfotohttps://www.alamy.de/image-license-details/?v=1https://www.alamy.de/professioneller-afroamerikanischer-forscher-der-kunstliches-fleisch-durch-das-mikroskop-betrachtet-image591073288.htmlRF2W9HM08–Professioneller afroamerikanischer Forscher, der künstliches Fleisch durch das Mikroskop betrachtet
 Junger asiatischer Laborassistent, der durch das Mikroskop schaut und wissenschaftliche Forschung durchführt Stockfotohttps://www.alamy.de/image-license-details/?v=1https://www.alamy.de/junger-asiatischer-laborassistent-der-durch-das-mikroskop-schaut-und-wissenschaftliche-forschung-durchfuhrt-image591073334.html
Junger asiatischer Laborassistent, der durch das Mikroskop schaut und wissenschaftliche Forschung durchführt Stockfotohttps://www.alamy.de/image-license-details/?v=1https://www.alamy.de/junger-asiatischer-laborassistent-der-durch-das-mikroskop-schaut-und-wissenschaftliche-forschung-durchfuhrt-image591073334.htmlRF2W9HM1X–Junger asiatischer Laborassistent, der durch das Mikroskop schaut und wissenschaftliche Forschung durchführt
 Junge asiatische Forscherin mit digitalem Tablet am Arbeitsplatz im Labor Stockfotohttps://www.alamy.de/image-license-details/?v=1https://www.alamy.de/junge-asiatische-forscherin-mit-digitalem-tablet-am-arbeitsplatz-im-labor-image591073580.html
Junge asiatische Forscherin mit digitalem Tablet am Arbeitsplatz im Labor Stockfotohttps://www.alamy.de/image-license-details/?v=1https://www.alamy.de/junge-asiatische-forscherin-mit-digitalem-tablet-am-arbeitsplatz-im-labor-image591073580.htmlRF2W9HMAM–Junge asiatische Forscherin mit digitalem Tablet am Arbeitsplatz im Labor
 Porträt eines lächelnden jungen Bloggers aus dem Nahen Osten in der Küche, der Spinat auf der Smartphone-Kamera zeigt, um Videos für seinen Kanal zu machen Stockfotohttps://www.alamy.de/image-license-details/?v=1https://www.alamy.de/portrat-eines-lachelnden-jungen-bloggers-aus-dem-nahen-osten-in-der-kuche-der-spinat-auf-der-smartphone-kamera-zeigt-um-videos-fur-seinen-kanal-zu-machen-image574147906.html
Porträt eines lächelnden jungen Bloggers aus dem Nahen Osten in der Küche, der Spinat auf der Smartphone-Kamera zeigt, um Videos für seinen Kanal zu machen Stockfotohttps://www.alamy.de/image-license-details/?v=1https://www.alamy.de/portrat-eines-lachelnden-jungen-bloggers-aus-dem-nahen-osten-in-der-kuche-der-spinat-auf-der-smartphone-kamera-zeigt-um-videos-fur-seinen-kanal-zu-machen-image574147906.htmlRF2TA2KEA–Porträt eines lächelnden jungen Bloggers aus dem Nahen Osten in der Küche, der Spinat auf der Smartphone-Kamera zeigt, um Videos für seinen Kanal zu machen
 Junger Mann aus dem Nahen Osten und glückliches hispanisches Mädchen mit Gemüse in den Händen, die sich anschauen, während sie in der Küche posieren Stockfotohttps://www.alamy.de/image-license-details/?v=1https://www.alamy.de/junger-mann-aus-dem-nahen-osten-und-gluckliches-hispanisches-madchen-mit-gemuse-in-den-handen-die-sich-anschauen-wahrend-sie-in-der-kuche-posieren-image574147934.html
Junger Mann aus dem Nahen Osten und glückliches hispanisches Mädchen mit Gemüse in den Händen, die sich anschauen, während sie in der Küche posieren Stockfotohttps://www.alamy.de/image-license-details/?v=1https://www.alamy.de/junger-mann-aus-dem-nahen-osten-und-gluckliches-hispanisches-madchen-mit-gemuse-in-den-handen-die-sich-anschauen-wahrend-sie-in-der-kuche-posieren-image574147934.htmlRF2TA2KFA–Junger Mann aus dem Nahen Osten und glückliches hispanisches Mädchen mit Gemüse in den Händen, die sich anschauen, während sie in der Küche posieren
 Mittelgroße Aufnahme des jungen Küchenchefs aus dem Nahen Osten, der Speisen in der Pfanne mit Spachtel umrührt, während er Videos auf dem Smartphone macht Stockfotohttps://www.alamy.de/image-license-details/?v=1https://www.alamy.de/mittelgrosse-aufnahme-des-jungen-kuchenchefs-aus-dem-nahen-osten-der-speisen-in-der-pfanne-mit-spachtel-umruhrt-wahrend-er-videos-auf-dem-smartphone-macht-image574147763.html
Mittelgroße Aufnahme des jungen Küchenchefs aus dem Nahen Osten, der Speisen in der Pfanne mit Spachtel umrührt, während er Videos auf dem Smartphone macht Stockfotohttps://www.alamy.de/image-license-details/?v=1https://www.alamy.de/mittelgrosse-aufnahme-des-jungen-kuchenchefs-aus-dem-nahen-osten-der-speisen-in-der-pfanne-mit-spachtel-umruhrt-wahrend-er-videos-auf-dem-smartphone-macht-image574147763.htmlRF2TA2K97–Mittelgroße Aufnahme des jungen Küchenchefs aus dem Nahen Osten, der Speisen in der Pfanne mit Spachtel umrührt, während er Videos auf dem Smartphone macht
 Nahaufnahme eines nicht erkennbaren Mannes, der einen Karton mit Eiern über dem Küchentisch hält Stockfotohttps://www.alamy.de/image-license-details/?v=1https://www.alamy.de/nahaufnahme-eines-nicht-erkennbaren-mannes-der-einen-karton-mit-eiern-uber-dem-kuchentisch-halt-image574147333.html
Nahaufnahme eines nicht erkennbaren Mannes, der einen Karton mit Eiern über dem Küchentisch hält Stockfotohttps://www.alamy.de/image-license-details/?v=1https://www.alamy.de/nahaufnahme-eines-nicht-erkennbaren-mannes-der-einen-karton-mit-eiern-uber-dem-kuchentisch-halt-image574147333.htmlRF2TA2JNW–Nahaufnahme eines nicht erkennbaren Mannes, der einen Karton mit Eiern über dem Küchentisch hält
 Mittelgroße Aufnahme des lächelnden jungen Küchenchefs aus dem Nahen Osten, der glücklich in der Kamera winkt, während er in der Küche posiert, im Kopierraum Stockfotohttps://www.alamy.de/image-license-details/?v=1https://www.alamy.de/mittelgrosse-aufnahme-des-lachelnden-jungen-kuchenchefs-aus-dem-nahen-osten-der-glucklich-in-der-kamera-winkt-wahrend-er-in-der-kuche-posiert-im-kopierraum-image574116389.html
Mittelgroße Aufnahme des lächelnden jungen Küchenchefs aus dem Nahen Osten, der glücklich in der Kamera winkt, während er in der Küche posiert, im Kopierraum Stockfotohttps://www.alamy.de/image-license-details/?v=1https://www.alamy.de/mittelgrosse-aufnahme-des-lachelnden-jungen-kuchenchefs-aus-dem-nahen-osten-der-glucklich-in-der-kamera-winkt-wahrend-er-in-der-kuche-posiert-im-kopierraum-image574116389.htmlRF2TA178N–Mittelgroße Aufnahme des lächelnden jungen Küchenchefs aus dem Nahen Osten, der glücklich in der Kamera winkt, während er in der Küche posiert, im Kopierraum
 Zugeschnittenes Bild eines Mannes, der Karton in der Selbstaufbewahrungseinheit klebt Stockfotohttps://www.alamy.de/image-license-details/?v=1https://www.alamy.de/zugeschnittenes-bild-eines-mannes-der-karton-in-der-selbstaufbewahrungseinheit-klebt-image573199885.html
Zugeschnittenes Bild eines Mannes, der Karton in der Selbstaufbewahrungseinheit klebt Stockfotohttps://www.alamy.de/image-license-details/?v=1https://www.alamy.de/zugeschnittenes-bild-eines-mannes-der-karton-in-der-selbstaufbewahrungseinheit-klebt-image573199885.htmlRF2T8FE8D–Zugeschnittenes Bild eines Mannes, der Karton in der Selbstaufbewahrungseinheit klebt
 Verriegeln Sie die geschlossene Tür des Lagergeräts mit den Gegenständen des Kunden Stockfotohttps://www.alamy.de/image-license-details/?v=1https://www.alamy.de/verriegeln-sie-die-geschlossene-tur-des-lagergerats-mit-den-gegenstanden-des-kunden-image573198302.html
Verriegeln Sie die geschlossene Tür des Lagergeräts mit den Gegenständen des Kunden Stockfotohttps://www.alamy.de/image-license-details/?v=1https://www.alamy.de/verriegeln-sie-die-geschlossene-tur-des-lagergerats-mit-den-gegenstanden-des-kunden-image573198302.htmlRF2T8FC7X–Verriegeln Sie die geschlossene Tür des Lagergeräts mit den Gegenständen des Kunden
 Der Kunde schiebt den Wagen mit Gegenständen in die große Einheit, die er in der Selbstaufbewahrung mietete Stockfotohttps://www.alamy.de/image-license-details/?v=1https://www.alamy.de/der-kunde-schiebt-den-wagen-mit-gegenstanden-in-die-grosse-einheit-die-er-in-der-selbstaufbewahrung-mietete-image573199445.html
Der Kunde schiebt den Wagen mit Gegenständen in die große Einheit, die er in der Selbstaufbewahrung mietete Stockfotohttps://www.alamy.de/image-license-details/?v=1https://www.alamy.de/der-kunde-schiebt-den-wagen-mit-gegenstanden-in-die-grosse-einheit-die-er-in-der-selbstaufbewahrung-mietete-image573199445.htmlRF2T8FDMN–Der Kunde schiebt den Wagen mit Gegenständen in die große Einheit, die er in der Selbstaufbewahrung mietete
 Eine junge Frau, die Kisten in eine fast voll bepackte Selbstlagereinrichtung legt Stockfotohttps://www.alamy.de/image-license-details/?v=1https://www.alamy.de/eine-junge-frau-die-kisten-in-eine-fast-voll-bepackte-selbstlagereinrichtung-legt-image573200326.html
Eine junge Frau, die Kisten in eine fast voll bepackte Selbstlagereinrichtung legt Stockfotohttps://www.alamy.de/image-license-details/?v=1https://www.alamy.de/eine-junge-frau-die-kisten-in-eine-fast-voll-bepackte-selbstlagereinrichtung-legt-image573200326.htmlRF2T8FET6–Eine junge Frau, die Kisten in eine fast voll bepackte Selbstlagereinrichtung legt
 Mann öffnet die Tür des Selbstspeichers, um Kisten mit Gegenständen darin zu platzieren Stockfotohttps://www.alamy.de/image-license-details/?v=1https://www.alamy.de/mann-offnet-die-tur-des-selbstspeichers-um-kisten-mit-gegenstanden-darin-zu-platzieren-image573199250.html
Mann öffnet die Tür des Selbstspeichers, um Kisten mit Gegenständen darin zu platzieren Stockfotohttps://www.alamy.de/image-license-details/?v=1https://www.alamy.de/mann-offnet-die-tur-des-selbstspeichers-um-kisten-mit-gegenstanden-darin-zu-platzieren-image573199250.htmlRF2T8FDDP–Mann öffnet die Tür des Selbstspeichers, um Kisten mit Gegenständen darin zu platzieren
 Ein Paar, das Kisten für den Auszug in Selbstlagerung gepackt hat, vermietet sie Stockfotohttps://www.alamy.de/image-license-details/?v=1https://www.alamy.de/ein-paar-das-kisten-fur-den-auszug-in-selbstlagerung-gepackt-hat-vermietet-sie-image573200357.html
Ein Paar, das Kisten für den Auszug in Selbstlagerung gepackt hat, vermietet sie Stockfotohttps://www.alamy.de/image-license-details/?v=1https://www.alamy.de/ein-paar-das-kisten-fur-den-auszug-in-selbstlagerung-gepackt-hat-vermietet-sie-image573200357.htmlRF2T8FEW9–Ein Paar, das Kisten für den Auszug in Selbstlagerung gepackt hat, vermietet sie
 Ein lächelndes Paar schiebt den Wagen mit Kartonschachteln zum Aufbewahrungsraum, um beim Umzug Gegenstände zu hinterlassen Stockfotohttps://www.alamy.de/image-license-details/?v=1https://www.alamy.de/ein-lachelndes-paar-schiebt-den-wagen-mit-kartonschachteln-zum-aufbewahrungsraum-um-beim-umzug-gegenstande-zu-hinterlassen-image573199433.html
Ein lächelndes Paar schiebt den Wagen mit Kartonschachteln zum Aufbewahrungsraum, um beim Umzug Gegenstände zu hinterlassen Stockfotohttps://www.alamy.de/image-license-details/?v=1https://www.alamy.de/ein-lachelndes-paar-schiebt-den-wagen-mit-kartonschachteln-zum-aufbewahrungsraum-um-beim-umzug-gegenstande-zu-hinterlassen-image573199433.htmlRF2T8FDM9–Ein lächelndes Paar schiebt den Wagen mit Kartonschachteln zum Aufbewahrungsraum, um beim Umzug Gegenstände zu hinterlassen
 Zwei liebevolle Töchter, die ihren Vater und ihre Mutter umarmen, sitzen am festlichen Tisch, serviert mit hausgemachten Speisen und Getränken zum Abendessen Stockfotohttps://www.alamy.de/image-license-details/?v=1https://www.alamy.de/zwei-liebevolle-tochter-die-ihren-vater-und-ihre-mutter-umarmen-sitzen-am-festlichen-tisch-serviert-mit-hausgemachten-speisen-und-getranken-zum-abendessen-image570870957.html
Zwei liebevolle Töchter, die ihren Vater und ihre Mutter umarmen, sitzen am festlichen Tisch, serviert mit hausgemachten Speisen und Getränken zum Abendessen Stockfotohttps://www.alamy.de/image-license-details/?v=1https://www.alamy.de/zwei-liebevolle-tochter-die-ihren-vater-und-ihre-mutter-umarmen-sitzen-am-festlichen-tisch-serviert-mit-hausgemachten-speisen-und-getranken-zum-abendessen-image570870957.htmlRF2T4NBMD–Zwei liebevolle Töchter, die ihren Vater und ihre Mutter umarmen, sitzen am festlichen Tisch, serviert mit hausgemachten Speisen und Getränken zum Abendessen
 Angestellter des Visumzentrums hat ein Interview mit dem Antragsteller, prüft Dokumente und stellt Fragen Stockfotohttps://www.alamy.de/image-license-details/?v=1https://www.alamy.de/angestellter-des-visumzentrums-hat-ein-interview-mit-dem-antragsteller-pruft-dokumente-und-stellt-fragen-image572529974.html
Angestellter des Visumzentrums hat ein Interview mit dem Antragsteller, prüft Dokumente und stellt Fragen Stockfotohttps://www.alamy.de/image-license-details/?v=1https://www.alamy.de/angestellter-des-visumzentrums-hat-ein-interview-mit-dem-antragsteller-pruft-dokumente-und-stellt-fragen-image572529974.htmlRF2T7CYR2–Angestellter des Visumzentrums hat ein Interview mit dem Antragsteller, prüft Dokumente und stellt Fragen
 Konzentrieren Sie sich auf das Gesicht eines beunruhigten Teenagers, das während einer Depression spät in der Nacht durch Cybermobbing beleuchtet wird Stockfotohttps://www.alamy.de/image-license-details/?v=1https://www.alamy.de/konzentrieren-sie-sich-auf-das-gesicht-eines-beunruhigten-teenagers-das-wahrend-einer-depression-spat-in-der-nacht-durch-cybermobbing-beleuchtet-wird-image570806447.html
Konzentrieren Sie sich auf das Gesicht eines beunruhigten Teenagers, das während einer Depression spät in der Nacht durch Cybermobbing beleuchtet wird Stockfotohttps://www.alamy.de/image-license-details/?v=1https://www.alamy.de/konzentrieren-sie-sich-auf-das-gesicht-eines-beunruhigten-teenagers-das-wahrend-einer-depression-spat-in-der-nacht-durch-cybermobbing-beleuchtet-wird-image570806447.htmlRF2T4JDCF–Konzentrieren Sie sich auf das Gesicht eines beunruhigten Teenagers, das während einer Depression spät in der Nacht durch Cybermobbing beleuchtet wird
 Ältere Frau, die sich während ihrer Arbeit im Café mit dem Handy unterhalten und Notizen in ihrem Notizblock macht Stockfotohttps://www.alamy.de/image-license-details/?v=1https://www.alamy.de/altere-frau-die-sich-wahrend-ihrer-arbeit-im-caf-mit-dem-handy-unterhalten-und-notizen-in-ihrem-notizblock-macht-image567135367.html
Ältere Frau, die sich während ihrer Arbeit im Café mit dem Handy unterhalten und Notizen in ihrem Notizblock macht Stockfotohttps://www.alamy.de/image-license-details/?v=1https://www.alamy.de/altere-frau-die-sich-wahrend-ihrer-arbeit-im-caf-mit-dem-handy-unterhalten-und-notizen-in-ihrem-notizblock-macht-image567135367.htmlRF2RXK6XF–Ältere Frau, die sich während ihrer Arbeit im Café mit dem Handy unterhalten und Notizen in ihrem Notizblock macht
 Pflegekräfte helfen älteren Frauen, mit dem Stock während ihres Spaziergangs im Freien zu gehen Stockfotohttps://www.alamy.de/image-license-details/?v=1https://www.alamy.de/pflegekrafte-helfen-alteren-frauen-mit-dem-stock-wahrend-ihres-spaziergangs-im-freien-zu-gehen-image567135829.html
Pflegekräfte helfen älteren Frauen, mit dem Stock während ihres Spaziergangs im Freien zu gehen Stockfotohttps://www.alamy.de/image-license-details/?v=1https://www.alamy.de/pflegekrafte-helfen-alteren-frauen-mit-dem-stock-wahrend-ihres-spaziergangs-im-freien-zu-gehen-image567135829.htmlRF2RXK7F1–Pflegekräfte helfen älteren Frauen, mit dem Stock während ihres Spaziergangs im Freien zu gehen
 Seniorenpaare, die ihren Spaziergang im Freien genießen, im Wald stehen und miteinander reden Stockfotohttps://www.alamy.de/image-license-details/?v=1https://www.alamy.de/seniorenpaare-die-ihren-spaziergang-im-freien-geniessen-im-wald-stehen-und-miteinander-reden-image567135873.html
Seniorenpaare, die ihren Spaziergang im Freien genießen, im Wald stehen und miteinander reden Stockfotohttps://www.alamy.de/image-license-details/?v=1https://www.alamy.de/seniorenpaare-die-ihren-spaziergang-im-freien-geniessen-im-wald-stehen-und-miteinander-reden-image567135873.htmlRF2RXK7GH–Seniorenpaare, die ihren Spaziergang im Freien genießen, im Wald stehen und miteinander reden
 Älteres Paar macht Selfie-Porträt am Telefon am See draußen Stockfotohttps://www.alamy.de/image-license-details/?v=1https://www.alamy.de/alteres-paar-macht-selfie-portrat-am-telefon-am-see-draussen-image567135939.html
Älteres Paar macht Selfie-Porträt am Telefon am See draußen Stockfotohttps://www.alamy.de/image-license-details/?v=1https://www.alamy.de/alteres-paar-macht-selfie-portrat-am-telefon-am-see-draussen-image567135939.htmlRF2RXK7JY–Älteres Paar macht Selfie-Porträt am Telefon am See draußen
 Eine multiethnische Gruppe von Studenten in Gewändern, die ihren Hut aufrichten und ihren Abschluss feiern Stockfotohttps://www.alamy.de/image-license-details/?v=1https://www.alamy.de/eine-multiethnische-gruppe-von-studenten-in-gewandern-die-ihren-hut-aufrichten-und-ihren-abschluss-feiern-image565954954.html
Eine multiethnische Gruppe von Studenten in Gewändern, die ihren Hut aufrichten und ihren Abschluss feiern Stockfotohttps://www.alamy.de/image-license-details/?v=1https://www.alamy.de/eine-multiethnische-gruppe-von-studenten-in-gewandern-die-ihren-hut-aufrichten-und-ihren-abschluss-feiern-image565954954.htmlRF2RTND8X–Eine multiethnische Gruppe von Studenten in Gewändern, die ihren Hut aufrichten und ihren Abschluss feiern
 Schwacher Blick auf die glückliche Gruppe von Studenten in Gewändern, die lachen und miteinander reden, während sie auf dem Campus stehen Stockfotohttps://www.alamy.de/image-license-details/?v=1https://www.alamy.de/schwacher-blick-auf-die-gluckliche-gruppe-von-studenten-in-gewandern-die-lachen-und-miteinander-reden-wahrend-sie-auf-dem-campus-stehen-image565954961.html
Schwacher Blick auf die glückliche Gruppe von Studenten in Gewändern, die lachen und miteinander reden, während sie auf dem Campus stehen Stockfotohttps://www.alamy.de/image-license-details/?v=1https://www.alamy.de/schwacher-blick-auf-die-gluckliche-gruppe-von-studenten-in-gewandern-die-lachen-und-miteinander-reden-wahrend-sie-auf-dem-campus-stehen-image565954961.htmlRF2RTND95–Schwacher Blick auf die glückliche Gruppe von Studenten in Gewändern, die lachen und miteinander reden, während sie auf dem Campus stehen
 Der Lehrer schüttelt den Schülern die Hand und gratuliert ihnen zum Abschluss der Universität, während sie draußen stehen Stockfotohttps://www.alamy.de/image-license-details/?v=1https://www.alamy.de/der-lehrer-schuttelt-den-schulern-die-hand-und-gratuliert-ihnen-zum-abschluss-der-universitat-wahrend-sie-draussen-stehen-image565955020.html
Der Lehrer schüttelt den Schülern die Hand und gratuliert ihnen zum Abschluss der Universität, während sie draußen stehen Stockfotohttps://www.alamy.de/image-license-details/?v=1https://www.alamy.de/der-lehrer-schuttelt-den-schulern-die-hand-und-gratuliert-ihnen-zum-abschluss-der-universitat-wahrend-sie-draussen-stehen-image565955020.htmlRF2RTNDB8–Der Lehrer schüttelt den Schülern die Hand und gratuliert ihnen zum Abschluss der Universität, während sie draußen stehen
 Ein afroamerikanischer Student machte Fotos mit seiner Familie im Freien Stockfotohttps://www.alamy.de/image-license-details/?v=1https://www.alamy.de/ein-afroamerikanischer-student-machte-fotos-mit-seiner-familie-im-freien-image565954846.html
Ein afroamerikanischer Student machte Fotos mit seiner Familie im Freien Stockfotohttps://www.alamy.de/image-license-details/?v=1https://www.alamy.de/ein-afroamerikanischer-student-machte-fotos-mit-seiner-familie-im-freien-image565954846.htmlRF2RTND52–Ein afroamerikanischer Student machte Fotos mit seiner Familie im Freien
 Smartphone-Bildschirm mit zwei jungen interkulturellen Bloggern, die in Online-Shops bestellte Waren bewerben und den Abonnenten beschreiben Stockfotohttps://www.alamy.de/image-license-details/?v=1https://www.alamy.de/smartphone-bildschirm-mit-zwei-jungen-interkulturellen-bloggern-die-in-online-shops-bestellte-waren-bewerben-und-den-abonnenten-beschreiben-image562034932.html
Smartphone-Bildschirm mit zwei jungen interkulturellen Bloggern, die in Online-Shops bestellte Waren bewerben und den Abonnenten beschreiben Stockfotohttps://www.alamy.de/image-license-details/?v=1https://www.alamy.de/smartphone-bildschirm-mit-zwei-jungen-interkulturellen-bloggern-die-in-online-shops-bestellte-waren-bewerben-und-den-abonnenten-beschreiben-image562034932.htmlRF2RJAW84–Smartphone-Bildschirm mit zwei jungen interkulturellen Bloggern, die in Online-Shops bestellte Waren bewerben und den Abonnenten beschreiben
 Glückliche junge Bloggerin zeigt auf den Smartphone-Bildschirm, während sie die Aufnahmetaste drückt, bevor sie über das Auspacken Livestreams macht Stockfotohttps://www.alamy.de/image-license-details/?v=1https://www.alamy.de/gluckliche-junge-bloggerin-zeigt-auf-den-smartphone-bildschirm-wahrend-sie-die-aufnahmetaste-druckt-bevor-sie-uber-das-auspacken-livestreams-macht-image562033303.html
Glückliche junge Bloggerin zeigt auf den Smartphone-Bildschirm, während sie die Aufnahmetaste drückt, bevor sie über das Auspacken Livestreams macht Stockfotohttps://www.alamy.de/image-license-details/?v=1https://www.alamy.de/gluckliche-junge-bloggerin-zeigt-auf-den-smartphone-bildschirm-wahrend-sie-die-aufnahmetaste-druckt-bevor-sie-uber-das-auspacken-livestreams-macht-image562033303.htmlRF2RJAR5Y–Glückliche junge Bloggerin zeigt auf den Smartphone-Bildschirm, während sie die Aufnahmetaste drückt, bevor sie über das Auspacken Livestreams macht
 Seitenansicht des jungen, hübschen Managers des Lagerraums, der vor dem Regal mit Paketen steht und die Anzahl der Bestellungen auf Kisten durchsucht Stockfotohttps://www.alamy.de/image-license-details/?v=1https://www.alamy.de/seitenansicht-des-jungen-hubschen-managers-des-lagerraums-der-vor-dem-regal-mit-paketen-steht-und-die-anzahl-der-bestellungen-auf-kisten-durchsucht-image562032486.html
Seitenansicht des jungen, hübschen Managers des Lagerraums, der vor dem Regal mit Paketen steht und die Anzahl der Bestellungen auf Kisten durchsucht Stockfotohttps://www.alamy.de/image-license-details/?v=1https://www.alamy.de/seitenansicht-des-jungen-hubschen-managers-des-lagerraums-der-vor-dem-regal-mit-paketen-steht-und-die-anzahl-der-bestellungen-auf-kisten-durchsucht-image562032486.htmlRF2RJAP4P–Seitenansicht des jungen, hübschen Managers des Lagerraums, der vor dem Regal mit Paketen steht und die Anzahl der Bestellungen auf Kisten durchsucht
 Junge Frau, die handgefertigte Vase verpackt in Sicherheitscellophan in Karton, während sie neben ihrem Freund während des Livestreams sitzt Stockfotohttps://www.alamy.de/image-license-details/?v=1https://www.alamy.de/junge-frau-die-handgefertigte-vase-verpackt-in-sicherheitscellophan-in-karton-wahrend-sie-neben-ihrem-freund-wahrend-des-livestreams-sitzt-image562034933.html
Junge Frau, die handgefertigte Vase verpackt in Sicherheitscellophan in Karton, während sie neben ihrem Freund während des Livestreams sitzt Stockfotohttps://www.alamy.de/image-license-details/?v=1https://www.alamy.de/junge-frau-die-handgefertigte-vase-verpackt-in-sicherheitscellophan-in-karton-wahrend-sie-neben-ihrem-freund-wahrend-des-livestreams-sitzt-image562034933.htmlRF2RJAW85–Junge Frau, die handgefertigte Vase verpackt in Sicherheitscellophan in Karton, während sie neben ihrem Freund während des Livestreams sitzt
 Glückliches junges interkulturelles Paar mit handgefertigten Vasen, die mit dem Online-Publikum sprechen, während sie Gegenstände ihrer Handwerkskunst und Kreativität zeigen und beschreiben Stockfotohttps://www.alamy.de/image-license-details/?v=1https://www.alamy.de/gluckliches-junges-interkulturelles-paar-mit-handgefertigten-vasen-die-mit-dem-online-publikum-sprechen-wahrend-sie-gegenstande-ihrer-handwerkskunst-und-kreativitat-zeigen-und-beschreiben-image562033583.html
Glückliches junges interkulturelles Paar mit handgefertigten Vasen, die mit dem Online-Publikum sprechen, während sie Gegenstände ihrer Handwerkskunst und Kreativität zeigen und beschreiben Stockfotohttps://www.alamy.de/image-license-details/?v=1https://www.alamy.de/gluckliches-junges-interkulturelles-paar-mit-handgefertigten-vasen-die-mit-dem-online-publikum-sprechen-wahrend-sie-gegenstande-ihrer-handwerkskunst-und-kreativitat-zeigen-und-beschreiben-image562033583.htmlRF2RJARFY–Glückliches junges interkulturelles Paar mit handgefertigten Vasen, die mit dem Online-Publikum sprechen, während sie Gegenstände ihrer Handwerkskunst und Kreativität zeigen und beschreiben
 Junger, seriöser afroamerikanischer Lagermanager mit einem Dokument, das den Stapel verpackter Kartons betrachtet, während er vor dem Regal steht Stockfotohttps://www.alamy.de/image-license-details/?v=1https://www.alamy.de/junger-serioser-afroamerikanischer-lagermanager-mit-einem-dokument-das-den-stapel-verpackter-kartons-betrachtet-wahrend-er-vor-dem-regal-steht-image562030176.html
Junger, seriöser afroamerikanischer Lagermanager mit einem Dokument, das den Stapel verpackter Kartons betrachtet, während er vor dem Regal steht Stockfotohttps://www.alamy.de/image-license-details/?v=1https://www.alamy.de/junger-serioser-afroamerikanischer-lagermanager-mit-einem-dokument-das-den-stapel-verpackter-kartons-betrachtet-wahrend-er-vor-dem-regal-steht-image562030176.htmlRF2RJAK68–Junger, seriöser afroamerikanischer Lagermanager mit einem Dokument, das den Stapel verpackter Kartons betrachtet, während er vor dem Regal steht
 Glückliche junge Bloggerin sitzt am Schreibtisch vor dem Smartphone und macht Livestream von neuen Vasen oder Blumentöpfen aus dem Online-Shop Stockfotohttps://www.alamy.de/image-license-details/?v=1https://www.alamy.de/gluckliche-junge-bloggerin-sitzt-am-schreibtisch-vor-dem-smartphone-und-macht-livestream-von-neuen-vasen-oder-blumentopfen-aus-dem-online-shop-image562033202.html
Glückliche junge Bloggerin sitzt am Schreibtisch vor dem Smartphone und macht Livestream von neuen Vasen oder Blumentöpfen aus dem Online-Shop Stockfotohttps://www.alamy.de/image-license-details/?v=1https://www.alamy.de/gluckliche-junge-bloggerin-sitzt-am-schreibtisch-vor-dem-smartphone-und-macht-livestream-von-neuen-vasen-oder-blumentopfen-aus-dem-online-shop-image562033202.htmlRF2RJAR2A–Glückliche junge Bloggerin sitzt am Schreibtisch vor dem Smartphone und macht Livestream von neuen Vasen oder Blumentöpfen aus dem Online-Shop
 Der junge afroamerikanische Blogger und Designer drückt die Aufnahmetaste auf dem Smartphone-Bildschirm, bevor er neue Kreativgegenstände präsentiert Stockfotohttps://www.alamy.de/image-license-details/?v=1https://www.alamy.de/der-junge-afroamerikanische-blogger-und-designer-druckt-die-aufnahmetaste-auf-dem-smartphone-bildschirm-bevor-er-neue-kreativgegenstande-prasentiert-image562033726.html
Der junge afroamerikanische Blogger und Designer drückt die Aufnahmetaste auf dem Smartphone-Bildschirm, bevor er neue Kreativgegenstände präsentiert Stockfotohttps://www.alamy.de/image-license-details/?v=1https://www.alamy.de/der-junge-afroamerikanische-blogger-und-designer-druckt-die-aufnahmetaste-auf-dem-smartphone-bildschirm-bevor-er-neue-kreativgegenstande-prasentiert-image562033726.htmlRF2RJARN2–Der junge afroamerikanische Blogger und Designer drückt die Aufnahmetaste auf dem Smartphone-Bildschirm, bevor er neue Kreativgegenstände präsentiert
 Seitenansicht des jungen, hübschen Managers des Lagerraums, der vor dem Regal mit Paketen steht und die Anzahl der Bestellungen auf Kisten durchsucht Stockfotohttps://www.alamy.de/image-license-details/?v=1https://www.alamy.de/seitenansicht-des-jungen-hubschen-managers-des-lagerraums-der-vor-dem-regal-mit-paketen-steht-und-die-anzahl-der-bestellungen-auf-kisten-durchsucht-image562032620.html
Seitenansicht des jungen, hübschen Managers des Lagerraums, der vor dem Regal mit Paketen steht und die Anzahl der Bestellungen auf Kisten durchsucht Stockfotohttps://www.alamy.de/image-license-details/?v=1https://www.alamy.de/seitenansicht-des-jungen-hubschen-managers-des-lagerraums-der-vor-dem-regal-mit-paketen-steht-und-die-anzahl-der-bestellungen-auf-kisten-durchsucht-image562032620.htmlRF2RJAP9G–Seitenansicht des jungen, hübschen Managers des Lagerraums, der vor dem Regal mit Paketen steht und die Anzahl der Bestellungen auf Kisten durchsucht
 Laptop mit leerem Bildschirm, der zwischen Dokumenten steht, und verpackte Kartons, in denen Bestellungen von Online-Shops-Kunden im Lagerraum enthalten sind Stockfotohttps://www.alamy.de/image-license-details/?v=1https://www.alamy.de/laptop-mit-leerem-bildschirm-der-zwischen-dokumenten-steht-und-verpackte-kartons-in-denen-bestellungen-von-online-shops-kunden-im-lagerraum-enthalten-sind-image562029474.html
Laptop mit leerem Bildschirm, der zwischen Dokumenten steht, und verpackte Kartons, in denen Bestellungen von Online-Shops-Kunden im Lagerraum enthalten sind Stockfotohttps://www.alamy.de/image-license-details/?v=1https://www.alamy.de/laptop-mit-leerem-bildschirm-der-zwischen-dokumenten-steht-und-verpackte-kartons-in-denen-bestellungen-von-online-shops-kunden-im-lagerraum-enthalten-sind-image562029474.htmlRF2RJAJ96–Laptop mit leerem Bildschirm, der zwischen Dokumenten steht, und verpackte Kartons, in denen Bestellungen von Online-Shops-Kunden im Lagerraum enthalten sind
 Afroamerikaner beginnt mit der Aufnahme oder dem Livestream, während er mit handgemachten Gegenständen am Schreibtisch sitzt und die Taste auf dem Smartphone-Bildschirm drückt Stockfotohttps://www.alamy.de/image-license-details/?v=1https://www.alamy.de/afroamerikaner-beginnt-mit-der-aufnahme-oder-dem-livestream-wahrend-er-mit-handgemachten-gegenstanden-am-schreibtisch-sitzt-und-die-taste-auf-dem-smartphone-bildschirm-druckt-image562033914.html
Afroamerikaner beginnt mit der Aufnahme oder dem Livestream, während er mit handgemachten Gegenständen am Schreibtisch sitzt und die Taste auf dem Smartphone-Bildschirm drückt Stockfotohttps://www.alamy.de/image-license-details/?v=1https://www.alamy.de/afroamerikaner-beginnt-mit-der-aufnahme-oder-dem-livestream-wahrend-er-mit-handgemachten-gegenstanden-am-schreibtisch-sitzt-und-die-taste-auf-dem-smartphone-bildschirm-druckt-image562033914.htmlRF2RJARYP–Afroamerikaner beginnt mit der Aufnahme oder dem Livestream, während er mit handgemachten Gegenständen am Schreibtisch sitzt und die Taste auf dem Smartphone-Bildschirm drückt
 Zwei glückliche junge Designer werben für handgefertigte Vasen während des Livestreams, während sie vor der Kamera eines mobilen Gadgets sitzen und mit dem Publikum sprechen Stockfotohttps://www.alamy.de/image-license-details/?v=1https://www.alamy.de/zwei-gluckliche-junge-designer-werben-fur-handgefertigte-vasen-wahrend-des-livestreams-wahrend-sie-vor-der-kamera-eines-mobilen-gadgets-sitzen-und-mit-dem-publikum-sprechen-image562033580.html
Zwei glückliche junge Designer werben für handgefertigte Vasen während des Livestreams, während sie vor der Kamera eines mobilen Gadgets sitzen und mit dem Publikum sprechen Stockfotohttps://www.alamy.de/image-license-details/?v=1https://www.alamy.de/zwei-gluckliche-junge-designer-werben-fur-handgefertigte-vasen-wahrend-des-livestreams-wahrend-sie-vor-der-kamera-eines-mobilen-gadgets-sitzen-und-mit-dem-publikum-sprechen-image562033580.htmlRF2RJARFT–Zwei glückliche junge Designer werben für handgefertigte Vasen während des Livestreams, während sie vor der Kamera eines mobilen Gadgets sitzen und mit dem Publikum sprechen
 Seitenansicht einer jungen Frau in Casualwear, die einen Stapel von Kartons auf das Regal legt, während sie vor der Rackwerbung steht und mit gepackten Online-Bestellungen arbeitet Stockfotohttps://www.alamy.de/image-license-details/?v=1https://www.alamy.de/seitenansicht-einer-jungen-frau-in-casualwear-die-einen-stapel-von-kartons-auf-das-regal-legt-wahrend-sie-vor-der-rackwerbung-steht-und-mit-gepackten-online-bestellungen-arbeitet-image562030383.html
Seitenansicht einer jungen Frau in Casualwear, die einen Stapel von Kartons auf das Regal legt, während sie vor der Rackwerbung steht und mit gepackten Online-Bestellungen arbeitet Stockfotohttps://www.alamy.de/image-license-details/?v=1https://www.alamy.de/seitenansicht-einer-jungen-frau-in-casualwear-die-einen-stapel-von-kartons-auf-das-regal-legt-wahrend-sie-vor-der-rackwerbung-steht-und-mit-gepackten-online-bestellungen-arbeitet-image562030383.htmlRF2RJAKDK–Seitenansicht einer jungen Frau in Casualwear, die einen Stapel von Kartons auf das Regal legt, während sie vor der Rackwerbung steht und mit gepackten Online-Bestellungen arbeitet
 Glückliche junge Frau mit einem Tablet, das persönliche Daten von Kunden auf Kartons ihres afroamerikanischen männlichen Kollegen überprüft Stockfotohttps://www.alamy.de/image-license-details/?v=1https://www.alamy.de/gluckliche-junge-frau-mit-einem-tablet-das-personliche-daten-von-kunden-auf-kartons-ihres-afroamerikanischen-mannlichen-kollegen-uberpruft-image562029746.html
Glückliche junge Frau mit einem Tablet, das persönliche Daten von Kunden auf Kartons ihres afroamerikanischen männlichen Kollegen überprüft Stockfotohttps://www.alamy.de/image-license-details/?v=1https://www.alamy.de/gluckliche-junge-frau-mit-einem-tablet-das-personliche-daten-von-kunden-auf-kartons-ihres-afroamerikanischen-mannlichen-kollegen-uberpruft-image562029746.htmlRF2RJAJJX–Glückliche junge Frau mit einem Tablet, das persönliche Daten von Kunden auf Kartons ihres afroamerikanischen männlichen Kollegen überprüft
 Junger afroamerikanischer Mann mit handgefertigter Vase in der Hand, der mit dem Online-Publikum spricht, während er während des Livestreams in der Smartphone-Kamera schaut Stockfotohttps://www.alamy.de/image-license-details/?v=1https://www.alamy.de/junger-afroamerikanischer-mann-mit-handgefertigter-vase-in-der-hand-der-mit-dem-online-publikum-spricht-wahrend-er-wahrend-des-livestreams-in-der-smartphone-kamera-schaut-image562033519.html
Junger afroamerikanischer Mann mit handgefertigter Vase in der Hand, der mit dem Online-Publikum spricht, während er während des Livestreams in der Smartphone-Kamera schaut Stockfotohttps://www.alamy.de/image-license-details/?v=1https://www.alamy.de/junger-afroamerikanischer-mann-mit-handgefertigter-vase-in-der-hand-der-mit-dem-online-publikum-spricht-wahrend-er-wahrend-des-livestreams-in-der-smartphone-kamera-schaut-image562033519.htmlRF2RJARDK–Junger afroamerikanischer Mann mit handgefertigter Vase in der Hand, der mit dem Online-Publikum spricht, während er während des Livestreams in der Smartphone-Kamera schaut
 Glückliche junge Managerin von Marketplace mit Scanner, der die Kamera anschaut, während er qr-Codes auf verpackten Kartons mit bestellten Waren überprüft Stockfotohttps://www.alamy.de/image-license-details/?v=1https://www.alamy.de/gluckliche-junge-managerin-von-marketplace-mit-scanner-der-die-kamera-anschaut-wahrend-er-qr-codes-auf-verpackten-kartons-mit-bestellten-waren-uberpruft-image562083483.html
Glückliche junge Managerin von Marketplace mit Scanner, der die Kamera anschaut, während er qr-Codes auf verpackten Kartons mit bestellten Waren überprüft Stockfotohttps://www.alamy.de/image-license-details/?v=1https://www.alamy.de/gluckliche-junge-managerin-von-marketplace-mit-scanner-der-die-kamera-anschaut-wahrend-er-qr-codes-auf-verpackten-kartons-mit-bestellten-waren-uberpruft-image562083483.htmlRF2RJD363–Glückliche junge Managerin von Marketplace mit Scanner, der die Kamera anschaut, während er qr-Codes auf verpackten Kartons mit bestellten Waren überprüft
 Porträt eines afroamerikanischen Lehrers, der zusammen mit den Schülern vor der Kamera lächelt, während sie im Klassenzimmer stehen Stockfotohttps://www.alamy.de/image-license-details/?v=1https://www.alamy.de/portrat-eines-afroamerikanischen-lehrers-der-zusammen-mit-den-schulern-vor-der-kamera-lachelt-wahrend-sie-im-klassenzimmer-stehen-image560129717.html
Porträt eines afroamerikanischen Lehrers, der zusammen mit den Schülern vor der Kamera lächelt, während sie im Klassenzimmer stehen Stockfotohttps://www.alamy.de/image-license-details/?v=1https://www.alamy.de/portrat-eines-afroamerikanischen-lehrers-der-zusammen-mit-den-schulern-vor-der-kamera-lachelt-wahrend-sie-im-klassenzimmer-stehen-image560129717.htmlRF2RF834N–Porträt eines afroamerikanischen Lehrers, der zusammen mit den Schülern vor der Kamera lächelt, während sie im Klassenzimmer stehen
 Lehrerin sitzt an ihrem Arbeitsplatz und bereitet sich auf den Unterricht im Klassenzimmer vor Stockfotohttps://www.alamy.de/image-license-details/?v=1https://www.alamy.de/lehrerin-sitzt-an-ihrem-arbeitsplatz-und-bereitet-sich-auf-den-unterricht-im-klassenzimmer-vor-image560131775.html
Lehrerin sitzt an ihrem Arbeitsplatz und bereitet sich auf den Unterricht im Klassenzimmer vor Stockfotohttps://www.alamy.de/image-license-details/?v=1https://www.alamy.de/lehrerin-sitzt-an-ihrem-arbeitsplatz-und-bereitet-sich-auf-den-unterricht-im-klassenzimmer-vor-image560131775.htmlRF2RF85P7–Lehrerin sitzt an ihrem Arbeitsplatz und bereitet sich auf den Unterricht im Klassenzimmer vor
 Schulkinder sitzen an Schreibtischen und heben die Hand, um die Frage des Lehrers zu beantworten Stockfotohttps://www.alamy.de/image-license-details/?v=1https://www.alamy.de/schulkinder-sitzen-an-schreibtischen-und-heben-die-hand-um-die-frage-des-lehrers-zu-beantworten-image560130062.html
Schulkinder sitzen an Schreibtischen und heben die Hand, um die Frage des Lehrers zu beantworten Stockfotohttps://www.alamy.de/image-license-details/?v=1https://www.alamy.de/schulkinder-sitzen-an-schreibtischen-und-heben-die-hand-um-die-frage-des-lehrers-zu-beantworten-image560130062.htmlRF2RF83H2–Schulkinder sitzen an Schreibtischen und heben die Hand, um die Frage des Lehrers zu beantworten
 Gruppe von Schulkindern, die an Schreibtischen sitzen und sich während des Unterrichts Notizen in ihren Notizbüchern machen Stockfotohttps://www.alamy.de/image-license-details/?v=1https://www.alamy.de/gruppe-von-schulkindern-die-an-schreibtischen-sitzen-und-sich-wahrend-des-unterrichts-notizen-in-ihren-notizbuchern-machen-image560129933.html
Gruppe von Schulkindern, die an Schreibtischen sitzen und sich während des Unterrichts Notizen in ihren Notizbüchern machen Stockfotohttps://www.alamy.de/image-license-details/?v=1https://www.alamy.de/gruppe-von-schulkindern-die-an-schreibtischen-sitzen-und-sich-wahrend-des-unterrichts-notizen-in-ihren-notizbuchern-machen-image560129933.htmlRF2RF83CD–Gruppe von Schulkindern, die an Schreibtischen sitzen und sich während des Unterrichts Notizen in ihren Notizbüchern machen
 Afroamerikanischer Lehrer, der den Schülern während des Unterrichts die Arbeit der Windmühle erklärt Stockfotohttps://www.alamy.de/image-license-details/?v=1https://www.alamy.de/afroamerikanischer-lehrer-der-den-schulern-wahrend-des-unterrichts-die-arbeit-der-windmuhle-erklart-image560132267.html
Afroamerikanischer Lehrer, der den Schülern während des Unterrichts die Arbeit der Windmühle erklärt Stockfotohttps://www.alamy.de/image-license-details/?v=1https://www.alamy.de/afroamerikanischer-lehrer-der-den-schulern-wahrend-des-unterrichts-die-arbeit-der-windmuhle-erklart-image560132267.htmlRF2RF86BR–Afroamerikanischer Lehrer, der den Schülern während des Unterrichts die Arbeit der Windmühle erklärt
 Arzt benutzt Massagegerät im medizinischen Verfahren mit dem Patienten, sie massiert seine Schmerzen zurück Stockfotohttps://www.alamy.de/image-license-details/?v=1https://www.alamy.de/arzt-benutzt-massagegerat-im-medizinischen-verfahren-mit-dem-patienten-sie-massiert-seine-schmerzen-zuruck-image560123680.html
Arzt benutzt Massagegerät im medizinischen Verfahren mit dem Patienten, sie massiert seine Schmerzen zurück Stockfotohttps://www.alamy.de/image-license-details/?v=1https://www.alamy.de/arzt-benutzt-massagegerat-im-medizinischen-verfahren-mit-dem-patienten-sie-massiert-seine-schmerzen-zuruck-image560123680.htmlRF2RF7RD4–Arzt benutzt Massagegerät im medizinischen Verfahren mit dem Patienten, sie massiert seine Schmerzen zurück
 Professioneller Arzt schaut in die Kamera, während er online mit dem Patienten spricht Stockfotohttps://www.alamy.de/image-license-details/?v=1https://www.alamy.de/professioneller-arzt-schaut-in-die-kamera-wahrend-er-online-mit-dem-patienten-spricht-image554429698.html
Professioneller Arzt schaut in die Kamera, während er online mit dem Patienten spricht Stockfotohttps://www.alamy.de/image-license-details/?v=1https://www.alamy.de/professioneller-arzt-schaut-in-die-kamera-wahrend-er-online-mit-dem-patienten-spricht-image554429698.htmlRF2R60CMJ–Professioneller Arzt schaut in die Kamera, während er online mit dem Patienten spricht
 Porträt einer mutter mit einem Kind, das vor der Kamera lächelt, zusammen mit einem Kinderarzt in der Praxis Stockfotohttps://www.alamy.de/image-license-details/?v=1https://www.alamy.de/portrat-einer-mutter-mit-einem-kind-das-vor-der-kamera-lachelt-zusammen-mit-einem-kinderarzt-in-der-praxis-image554429682.html
Porträt einer mutter mit einem Kind, das vor der Kamera lächelt, zusammen mit einem Kinderarzt in der Praxis Stockfotohttps://www.alamy.de/image-license-details/?v=1https://www.alamy.de/portrat-einer-mutter-mit-einem-kind-das-vor-der-kamera-lachelt-zusammen-mit-einem-kinderarzt-in-der-praxis-image554429682.htmlRF2R60CM2–Porträt einer mutter mit einem Kind, das vor der Kamera lächelt, zusammen mit einem Kinderarzt in der Praxis
 Vertikalbild eines Arztes im weißen Kittel, der während eines Videogesprächs in der Praxis in die Kamera schaut Stockfotohttps://www.alamy.de/image-license-details/?v=1https://www.alamy.de/vertikalbild-eines-arztes-im-weissen-kittel-der-wahrend-eines-videogesprachs-in-der-praxis-in-die-kamera-schaut-image554429706.html
Vertikalbild eines Arztes im weißen Kittel, der während eines Videogesprächs in der Praxis in die Kamera schaut Stockfotohttps://www.alamy.de/image-license-details/?v=1https://www.alamy.de/vertikalbild-eines-arztes-im-weissen-kittel-der-wahrend-eines-videogesprachs-in-der-praxis-in-die-kamera-schaut-image554429706.htmlRF2R60CMX–Vertikalbild eines Arztes im weißen Kittel, der während eines Videogesprächs in der Praxis in die Kamera schaut
 Porträt einer jungen Bloggerin, die sich online ein Video für ihren Blog ansieht Stockfotohttps://www.alamy.de/image-license-details/?v=1https://www.alamy.de/portrat-einer-jungen-bloggerin-die-sich-online-ein-video-fur-ihren-blog-ansieht-image519561628.html
Porträt einer jungen Bloggerin, die sich online ein Video für ihren Blog ansieht Stockfotohttps://www.alamy.de/image-license-details/?v=1https://www.alamy.de/portrat-einer-jungen-bloggerin-die-sich-online-ein-video-fur-ihren-blog-ansieht-image519561628.htmlRF2N5824C–Porträt einer jungen Bloggerin, die sich online ein Video für ihren Blog ansieht
 Teenager, die mit dem Laptop auf dem Boden saß und ihre Mutter ärgerte, während sie sich ernsthaft mit ihr im Zimmer zu Hause unterhielt Stockfotohttps://www.alamy.de/image-license-details/?v=1https://www.alamy.de/teenager-die-mit-dem-laptop-auf-dem-boden-sass-und-ihre-mutter-argerte-wahrend-sie-sich-ernsthaft-mit-ihr-im-zimmer-zu-hause-unterhielt-image519512826.html
Teenager, die mit dem Laptop auf dem Boden saß und ihre Mutter ärgerte, während sie sich ernsthaft mit ihr im Zimmer zu Hause unterhielt Stockfotohttps://www.alamy.de/image-license-details/?v=1https://www.alamy.de/teenager-die-mit-dem-laptop-auf-dem-boden-sass-und-ihre-mutter-argerte-wahrend-sie-sich-ernsthaft-mit-ihr-im-zimmer-zu-hause-unterhielt-image519512826.htmlRF2N55RWE–Teenager, die mit dem Laptop auf dem Boden saß und ihre Mutter ärgerte, während sie sich ernsthaft mit ihr im Zimmer zu Hause unterhielt
 Teenager-Mädchen, die auf dem Sofa liegt und mit dem Smartphone spielt, während ihre mutter sie beschimpft, weil sie lange Zeit Geräte benutzt hat Stockfotohttps://www.alamy.de/image-license-details/?v=1https://www.alamy.de/teenager-madchen-die-auf-dem-sofa-liegt-und-mit-dem-smartphone-spielt-wahrend-ihre-mutter-sie-beschimpft-weil-sie-lange-zeit-gerate-benutzt-hat-image519510044.html
Teenager-Mädchen, die auf dem Sofa liegt und mit dem Smartphone spielt, während ihre mutter sie beschimpft, weil sie lange Zeit Geräte benutzt hat Stockfotohttps://www.alamy.de/image-license-details/?v=1https://www.alamy.de/teenager-madchen-die-auf-dem-sofa-liegt-und-mit-dem-smartphone-spielt-wahrend-ihre-mutter-sie-beschimpft-weil-sie-lange-zeit-gerate-benutzt-hat-image519510044.htmlRF2N55MA4–Teenager-Mädchen, die auf dem Sofa liegt und mit dem Smartphone spielt, während ihre mutter sie beschimpft, weil sie lange Zeit Geräte benutzt hat
 Mutter umarmt ihr Kind im Teenageralter und drückt ihre Fürsorge aus, während sie im Wohnzimmer auf dem Sofa sitzt Stockfotohttps://www.alamy.de/image-license-details/?v=1https://www.alamy.de/mutter-umarmt-ihr-kind-im-teenageralter-und-druckt-ihre-fursorge-aus-wahrend-sie-im-wohnzimmer-auf-dem-sofa-sitzt-image519521079.html
Mutter umarmt ihr Kind im Teenageralter und drückt ihre Fürsorge aus, während sie im Wohnzimmer auf dem Sofa sitzt Stockfotohttps://www.alamy.de/image-license-details/?v=1https://www.alamy.de/mutter-umarmt-ihr-kind-im-teenageralter-und-druckt-ihre-fursorge-aus-wahrend-sie-im-wohnzimmer-auf-dem-sofa-sitzt-image519521079.htmlRF2N566C7–Mutter umarmt ihr Kind im Teenageralter und drückt ihre Fürsorge aus, während sie im Wohnzimmer auf dem Sofa sitzt
 Porträt eines Mädchens im Teenageralter, das ihr Gesicht mit den Händen bedeckt, während es Musik über Kopfhörer hört, isoliert auf orangefarbenem Hintergrund Stockfotohttps://www.alamy.de/image-license-details/?v=1https://www.alamy.de/portrat-eines-madchens-im-teenageralter-das-ihr-gesicht-mit-den-handen-bedeckt-wahrend-es-musik-uber-kopfhorer-hort-isoliert-auf-orangefarbenem-hintergrund-image519539888.html
Porträt eines Mädchens im Teenageralter, das ihr Gesicht mit den Händen bedeckt, während es Musik über Kopfhörer hört, isoliert auf orangefarbenem Hintergrund Stockfotohttps://www.alamy.de/image-license-details/?v=1https://www.alamy.de/portrat-eines-madchens-im-teenageralter-das-ihr-gesicht-mit-den-handen-bedeckt-wahrend-es-musik-uber-kopfhorer-hort-isoliert-auf-orangefarbenem-hintergrund-image519539888.htmlRF2N572C0–Porträt eines Mädchens im Teenageralter, das ihr Gesicht mit den Händen bedeckt, während es Musik über Kopfhörer hört, isoliert auf orangefarbenem Hintergrund
 Teenager mit kabellosen Kopfhörern, die am Tisch vor dem Computermonitor sitzt und mit ihrer Mutter Computerspiele spielt und ihr eine Bemerkung macht Stockfotohttps://www.alamy.de/image-license-details/?v=1https://www.alamy.de/teenager-mit-kabellosen-kopfhorern-die-am-tisch-vor-dem-computermonitor-sitzt-und-mit-ihrer-mutter-computerspiele-spielt-und-ihr-eine-bemerkung-macht-image519526570.html
Teenager mit kabellosen Kopfhörern, die am Tisch vor dem Computermonitor sitzt und mit ihrer Mutter Computerspiele spielt und ihr eine Bemerkung macht Stockfotohttps://www.alamy.de/image-license-details/?v=1https://www.alamy.de/teenager-mit-kabellosen-kopfhorern-die-am-tisch-vor-dem-computermonitor-sitzt-und-mit-ihrer-mutter-computerspiele-spielt-und-ihr-eine-bemerkung-macht-image519526570.htmlRF2N56DCA–Teenager mit kabellosen Kopfhörern, die am Tisch vor dem Computermonitor sitzt und mit ihrer Mutter Computerspiele spielt und ihr eine Bemerkung macht
 Die Mutter saß zusammen mit ihrer Tochter auf dem Sofa und umarmte sie, sie tröstete sie während einer Depression Stockfotohttps://www.alamy.de/image-license-details/?v=1https://www.alamy.de/die-mutter-sass-zusammen-mit-ihrer-tochter-auf-dem-sofa-und-umarmte-sie-sie-trostete-sie-wahrend-einer-depression-image519519420.html
Die Mutter saß zusammen mit ihrer Tochter auf dem Sofa und umarmte sie, sie tröstete sie während einer Depression Stockfotohttps://www.alamy.de/image-license-details/?v=1https://www.alamy.de/die-mutter-sass-zusammen-mit-ihrer-tochter-auf-dem-sofa-und-umarmte-sie-sie-trostete-sie-wahrend-einer-depression-image519519420.htmlRF2N56490–Die Mutter saß zusammen mit ihrer Tochter auf dem Sofa und umarmte sie, sie tröstete sie während einer Depression
 Porträt einer jungen Bloggerin, die sich online ein Video für ihren Blog ansieht Stockfotohttps://www.alamy.de/image-license-details/?v=1https://www.alamy.de/portrat-einer-jungen-bloggerin-die-sich-online-ein-video-fur-ihren-blog-ansieht-image519536613.html
Porträt einer jungen Bloggerin, die sich online ein Video für ihren Blog ansieht Stockfotohttps://www.alamy.de/image-license-details/?v=1https://www.alamy.de/portrat-einer-jungen-bloggerin-die-sich-online-ein-video-fur-ihren-blog-ansieht-image519536613.htmlRF2N56X71–Porträt einer jungen Bloggerin, die sich online ein Video für ihren Blog ansieht
 Nahaufnahme eines Mädchens im Teenageralter mit kabellosen Kopfhörern, während es am Schreibtisch vor dem Computermonitor sitzt Stockfotohttps://www.alamy.de/image-license-details/?v=1https://www.alamy.de/nahaufnahme-eines-madchens-im-teenageralter-mit-kabellosen-kopfhorern-wahrend-es-am-schreibtisch-vor-dem-computermonitor-sitzt-image519534684.html
Nahaufnahme eines Mädchens im Teenageralter mit kabellosen Kopfhörern, während es am Schreibtisch vor dem Computermonitor sitzt Stockfotohttps://www.alamy.de/image-license-details/?v=1https://www.alamy.de/nahaufnahme-eines-madchens-im-teenageralter-mit-kabellosen-kopfhorern-wahrend-es-am-schreibtisch-vor-dem-computermonitor-sitzt-image519534684.htmlRF2N56RP4–Nahaufnahme eines Mädchens im Teenageralter mit kabellosen Kopfhörern, während es am Schreibtisch vor dem Computermonitor sitzt
 Junge Bloggerin steht auf einem Stativ vor dem Smartphone und tanzt online für ihre Anhänger Stockfotohttps://www.alamy.de/image-license-details/?v=1https://www.alamy.de/junge-bloggerin-steht-auf-einem-stativ-vor-dem-smartphone-und-tanzt-online-fur-ihre-anhanger-image519536259.html
Junge Bloggerin steht auf einem Stativ vor dem Smartphone und tanzt online für ihre Anhänger Stockfotohttps://www.alamy.de/image-license-details/?v=1https://www.alamy.de/junge-bloggerin-steht-auf-einem-stativ-vor-dem-smartphone-und-tanzt-online-fur-ihre-anhanger-image519536259.htmlRF2N56WPB–Junge Bloggerin steht auf einem Stativ vor dem Smartphone und tanzt online für ihre Anhänger
 Horizontales Bild eines modernen Zimmers mit Teenager und Schreibtisch mit Computermonitor Stockfotohttps://www.alamy.de/image-license-details/?v=1https://www.alamy.de/horizontales-bild-eines-modernen-zimmers-mit-teenager-und-schreibtisch-mit-computermonitor-image519541192.html
Horizontales Bild eines modernen Zimmers mit Teenager und Schreibtisch mit Computermonitor Stockfotohttps://www.alamy.de/image-license-details/?v=1https://www.alamy.de/horizontales-bild-eines-modernen-zimmers-mit-teenager-und-schreibtisch-mit-computermonitor-image519541192.htmlRF2N5742G–Horizontales Bild eines modernen Zimmers mit Teenager und Schreibtisch mit Computermonitor
 Helles großes Apartment mit komfortablem Sofa in der Mitte und anderen modernen Möbeln Stockfotohttps://www.alamy.de/image-license-details/?v=1https://www.alamy.de/helles-grosses-apartment-mit-komfortablem-sofa-in-der-mitte-und-anderen-modernen-mobeln-image519525371.html
Helles großes Apartment mit komfortablem Sofa in der Mitte und anderen modernen Möbeln Stockfotohttps://www.alamy.de/image-license-details/?v=1https://www.alamy.de/helles-grosses-apartment-mit-komfortablem-sofa-in-der-mitte-und-anderen-modernen-mobeln-image519525371.htmlRF2N56BWF–Helles großes Apartment mit komfortablem Sofa in der Mitte und anderen modernen Möbeln
 Glückliches Teenager Mädchen umarmte ihre Mutter und lächelte, während sie sich auf dem Sofa im Zimmer ausruhten Stockfotohttps://www.alamy.de/image-license-details/?v=1https://www.alamy.de/gluckliches-teenager-madchen-umarmte-ihre-mutter-und-lachelte-wahrend-sie-sich-auf-dem-sofa-im-zimmer-ausruhten-image519559953.html
Glückliches Teenager Mädchen umarmte ihre Mutter und lächelte, während sie sich auf dem Sofa im Zimmer ausruhten Stockfotohttps://www.alamy.de/image-license-details/?v=1https://www.alamy.de/gluckliches-teenager-madchen-umarmte-ihre-mutter-und-lachelte-wahrend-sie-sich-auf-dem-sofa-im-zimmer-ausruhten-image519559953.htmlRF2N5800H–Glückliches Teenager Mädchen umarmte ihre Mutter und lächelte, während sie sich auf dem Sofa im Zimmer ausruhten
 Teenager-Mädchen, die zusammen mit ihrer mutter Fotos auf dem Smartphone anschauen, sie sitzen auf dem Sofa, reden und lächeln Stockfotohttps://www.alamy.de/image-license-details/?v=1https://www.alamy.de/teenager-madchen-die-zusammen-mit-ihrer-mutter-fotos-auf-dem-smartphone-anschauen-sie-sitzen-auf-dem-sofa-reden-und-lacheln-image519523444.html
Teenager-Mädchen, die zusammen mit ihrer mutter Fotos auf dem Smartphone anschauen, sie sitzen auf dem Sofa, reden und lächeln Stockfotohttps://www.alamy.de/image-license-details/?v=1https://www.alamy.de/teenager-madchen-die-zusammen-mit-ihrer-mutter-fotos-auf-dem-smartphone-anschauen-sie-sitzen-auf-dem-sofa-reden-und-lacheln-image519523444.htmlRF2N569CM–Teenager-Mädchen, die zusammen mit ihrer mutter Fotos auf dem Smartphone anschauen, sie sitzen auf dem Sofa, reden und lächeln
 Porträt eines Teenagers, das in die Kamera schaut, während er ein Video für ihren Blog in ihrem Schlafzimmer aufnimmt Stockfotohttps://www.alamy.de/image-license-details/?v=1https://www.alamy.de/portrat-eines-teenagers-das-in-die-kamera-schaut-wahrend-er-ein-video-fur-ihren-blog-in-ihrem-schlafzimmer-aufnimmt-image519536334.html
Porträt eines Teenagers, das in die Kamera schaut, während er ein Video für ihren Blog in ihrem Schlafzimmer aufnimmt Stockfotohttps://www.alamy.de/image-license-details/?v=1https://www.alamy.de/portrat-eines-teenagers-das-in-die-kamera-schaut-wahrend-er-ein-video-fur-ihren-blog-in-ihrem-schlafzimmer-aufnimmt-image519536334.htmlRF2N56WW2–Porträt eines Teenagers, das in die Kamera schaut, während er ein Video für ihren Blog in ihrem Schlafzimmer aufnimmt
 Horizontales Bild eines modernen Teenager-Schlafzimmers mit komfortablem Bett Stockfotohttps://www.alamy.de/image-license-details/?v=1https://www.alamy.de/horizontales-bild-eines-modernen-teenager-schlafzimmers-mit-komfortablem-bett-image519541803.html
Horizontales Bild eines modernen Teenager-Schlafzimmers mit komfortablem Bett Stockfotohttps://www.alamy.de/image-license-details/?v=1https://www.alamy.de/horizontales-bild-eines-modernen-teenager-schlafzimmers-mit-komfortablem-bett-image519541803.htmlRF2N574TB–Horizontales Bild eines modernen Teenager-Schlafzimmers mit komfortablem Bett
 Porträt eines süßen Teenagers mit Brille, das isoliert auf orangefarbenem Hintergrund in die Kamera schaut Stockfotohttps://www.alamy.de/image-license-details/?v=1https://www.alamy.de/portrat-eines-sussen-teenagers-mit-brille-das-isoliert-auf-orangefarbenem-hintergrund-in-die-kamera-schaut-image519537278.html
Porträt eines süßen Teenagers mit Brille, das isoliert auf orangefarbenem Hintergrund in die Kamera schaut Stockfotohttps://www.alamy.de/image-license-details/?v=1https://www.alamy.de/portrat-eines-sussen-teenagers-mit-brille-das-isoliert-auf-orangefarbenem-hintergrund-in-die-kamera-schaut-image519537278.htmlRF2N56Y2P–Porträt eines süßen Teenagers mit Brille, das isoliert auf orangefarbenem Hintergrund in die Kamera schaut
 Die Familie hat Spaß mit ihrer Tochter im Freien, während sie im Wald spazieren geht Stockfotohttps://www.alamy.de/image-license-details/?v=1https://www.alamy.de/die-familie-hat-spass-mit-ihrer-tochter-im-freien-wahrend-sie-im-wald-spazieren-geht-image504755461.html
Die Familie hat Spaß mit ihrer Tochter im Freien, während sie im Wald spazieren geht Stockfotohttps://www.alamy.de/image-license-details/?v=1https://www.alamy.de/die-familie-hat-spass-mit-ihrer-tochter-im-freien-wahrend-sie-im-wald-spazieren-geht-image504755461.htmlRF2M95GMN–Die Familie hat Spaß mit ihrer Tochter im Freien, während sie im Wald spazieren geht
 Porträt einer glücklichen Familie mit ihrer Tochter, die zusammen vor der Kamera lächelt und im Winterwald steht Stockfotohttps://www.alamy.de/image-license-details/?v=1https://www.alamy.de/portrat-einer-glucklichen-familie-mit-ihrer-tochter-die-zusammen-vor-der-kamera-lachelt-und-im-winterwald-steht-image504755732.html
Porträt einer glücklichen Familie mit ihrer Tochter, die zusammen vor der Kamera lächelt und im Winterwald steht Stockfotohttps://www.alamy.de/image-license-details/?v=1https://www.alamy.de/portrat-einer-glucklichen-familie-mit-ihrer-tochter-die-zusammen-vor-der-kamera-lachelt-und-im-winterwald-steht-image504755732.htmlRF2M95H2C–Porträt einer glücklichen Familie mit ihrer Tochter, die zusammen vor der Kamera lächelt und im Winterwald steht
 Nahaufnahme eines jungen Paares, das während seines Picknickens im Wald heißen Tee aus der Thermoskanne trinkt Stockfotohttps://www.alamy.de/image-license-details/?v=1https://www.alamy.de/nahaufnahme-eines-jungen-paares-das-wahrend-seines-picknickens-im-wald-heissen-tee-aus-der-thermoskanne-trinkt-image504754760.html
Nahaufnahme eines jungen Paares, das während seines Picknickens im Wald heißen Tee aus der Thermoskanne trinkt Stockfotohttps://www.alamy.de/image-license-details/?v=1https://www.alamy.de/nahaufnahme-eines-jungen-paares-das-wahrend-seines-picknickens-im-wald-heissen-tee-aus-der-thermoskanne-trinkt-image504754760.htmlRF2M95FRM–Nahaufnahme eines jungen Paares, das während seines Picknickens im Wald heißen Tee aus der Thermoskanne trinkt
 Glücklicher Vater, der seine Tochter auf den Rücksitz setzte und sie vor der Reise anschnallte Stockfotohttps://www.alamy.de/image-license-details/?v=1https://www.alamy.de/glucklicher-vater-der-seine-tochter-auf-den-rucksitz-setzte-und-sie-vor-der-reise-anschnallte-image504754567.html
Glücklicher Vater, der seine Tochter auf den Rücksitz setzte und sie vor der Reise anschnallte Stockfotohttps://www.alamy.de/image-license-details/?v=1https://www.alamy.de/glucklicher-vater-der-seine-tochter-auf-den-rucksitz-setzte-und-sie-vor-der-reise-anschnallte-image504754567.htmlRF2M95FGR–Glücklicher Vater, der seine Tochter auf den Rücksitz setzte und sie vor der Reise anschnallte
 Horizontales Bild des Winterwaldes mit verschneiten Bäumen und Wanderwegen Stockfotohttps://www.alamy.de/image-license-details/?v=1https://www.alamy.de/horizontales-bild-des-winterwaldes-mit-verschneiten-baumen-und-wanderwegen-image504754692.html
Horizontales Bild des Winterwaldes mit verschneiten Bäumen und Wanderwegen Stockfotohttps://www.alamy.de/image-license-details/?v=1https://www.alamy.de/horizontales-bild-des-winterwaldes-mit-verschneiten-baumen-und-wanderwegen-image504754692.htmlRF2M95FN8–Horizontales Bild des Winterwaldes mit verschneiten Bäumen und Wanderwegen
 Junge Frau trinkt Tee aus Thermoskannen während des Picknickens im Winterwald Stockfotohttps://www.alamy.de/image-license-details/?v=1https://www.alamy.de/junge-frau-trinkt-tee-aus-thermoskannen-wahrend-des-picknickens-im-winterwald-image504755464.html
Junge Frau trinkt Tee aus Thermoskannen während des Picknickens im Winterwald Stockfotohttps://www.alamy.de/image-license-details/?v=1https://www.alamy.de/junge-frau-trinkt-tee-aus-thermoskannen-wahrend-des-picknickens-im-winterwald-image504755464.htmlRF2M95GMT–Junge Frau trinkt Tee aus Thermoskannen während des Picknickens im Winterwald
 Eine dreiköpfige Familie, die während ihres Urlaubs mit einem Hund im Winterwald spazieren geht Stockfotohttps://www.alamy.de/image-license-details/?v=1https://www.alamy.de/eine-dreikopfige-familie-die-wahrend-ihres-urlaubs-mit-einem-hund-im-winterwald-spazieren-geht-image504756212.html
Eine dreiköpfige Familie, die während ihres Urlaubs mit einem Hund im Winterwald spazieren geht Stockfotohttps://www.alamy.de/image-license-details/?v=1https://www.alamy.de/eine-dreikopfige-familie-die-wahrend-ihres-urlaubs-mit-einem-hund-im-winterwald-spazieren-geht-image504756212.htmlRF2M95HKG–Eine dreiköpfige Familie, die während ihres Urlaubs mit einem Hund im Winterwald spazieren geht
 Ein bärtiger Mann, der sich auf das Fahren konzentriert, sitzt im Auto zusammen mit seiner Freundin Stockfotohttps://www.alamy.de/image-license-details/?v=1https://www.alamy.de/ein-bartiger-mann-der-sich-auf-das-fahren-konzentriert-sitzt-im-auto-zusammen-mit-seiner-freundin-image504754397.html
Ein bärtiger Mann, der sich auf das Fahren konzentriert, sitzt im Auto zusammen mit seiner Freundin Stockfotohttps://www.alamy.de/image-license-details/?v=1https://www.alamy.de/ein-bartiger-mann-der-sich-auf-das-fahren-konzentriert-sitzt-im-auto-zusammen-mit-seiner-freundin-image504754397.htmlRF2M95FAN–Ein bärtiger Mann, der sich auf das Fahren konzentriert, sitzt im Auto zusammen mit seiner Freundin
 Porträt einer glücklichen Familie, die vor der Kamera lächelt, während sie mit dem Hund im Winterwald spazieren geht Stockfotohttps://www.alamy.de/image-license-details/?v=1https://www.alamy.de/portrat-einer-glucklichen-familie-die-vor-der-kamera-lachelt-wahrend-sie-mit-dem-hund-im-winterwald-spazieren-geht-image504756316.html
Porträt einer glücklichen Familie, die vor der Kamera lächelt, während sie mit dem Hund im Winterwald spazieren geht Stockfotohttps://www.alamy.de/image-license-details/?v=1https://www.alamy.de/portrat-einer-glucklichen-familie-die-vor-der-kamera-lachelt-wahrend-sie-mit-dem-hund-im-winterwald-spazieren-geht-image504756316.htmlRF2M95HR8–Porträt einer glücklichen Familie, die vor der Kamera lächelt, während sie mit dem Hund im Winterwald spazieren geht
 Ein junges glückliches Paar, das Händchen hält und im Winter zusammen im Wald spaziert Stockfotohttps://www.alamy.de/image-license-details/?v=1https://www.alamy.de/ein-junges-gluckliches-paar-das-handchen-halt-und-im-winter-zusammen-im-wald-spaziert-image504755138.html
Ein junges glückliches Paar, das Händchen hält und im Winter zusammen im Wald spaziert Stockfotohttps://www.alamy.de/image-license-details/?v=1https://www.alamy.de/ein-junges-gluckliches-paar-das-handchen-halt-und-im-winter-zusammen-im-wald-spaziert-image504755138.htmlRF2M95G96–Ein junges glückliches Paar, das Händchen hält und im Winter zusammen im Wald spaziert
 Blick aus dem niedrigen Winkel auf verschneite Kiefern im Winterwald Stockfotohttps://www.alamy.de/image-license-details/?v=1https://www.alamy.de/blick-aus-dem-niedrigen-winkel-auf-verschneite-kiefern-im-winterwald-image504754970.html
Blick aus dem niedrigen Winkel auf verschneite Kiefern im Winterwald Stockfotohttps://www.alamy.de/image-license-details/?v=1https://www.alamy.de/blick-aus-dem-niedrigen-winkel-auf-verschneite-kiefern-im-winterwald-image504754970.htmlRF2M95G36–Blick aus dem niedrigen Winkel auf verschneite Kiefern im Winterwald
 Familienfahrten mit der Tochter und Spaziergänge mit dem Hund im Wald während der Winterferien Stockfotohttps://www.alamy.de/image-license-details/?v=1https://www.alamy.de/familienfahrten-mit-der-tochter-und-spaziergange-mit-dem-hund-im-wald-wahrend-der-winterferien-image504755141.html
Familienfahrten mit der Tochter und Spaziergänge mit dem Hund im Wald während der Winterferien Stockfotohttps://www.alamy.de/image-license-details/?v=1https://www.alamy.de/familienfahrten-mit-der-tochter-und-spaziergange-mit-dem-hund-im-wald-wahrend-der-winterferien-image504755141.htmlRF2M95G99–Familienfahrten mit der Tochter und Spaziergänge mit dem Hund im Wald während der Winterferien
 Porträt einer glücklichen dreiköpfigen Familie, die während des Spaziergangs im Park Schnee aus den Händen bläst Stockfotohttps://www.alamy.de/image-license-details/?v=1https://www.alamy.de/portrat-einer-glucklichen-dreikopfigen-familie-die-wahrend-des-spaziergangs-im-park-schnee-aus-den-handen-blast-image504756010.html
Porträt einer glücklichen dreiköpfigen Familie, die während des Spaziergangs im Park Schnee aus den Händen bläst Stockfotohttps://www.alamy.de/image-license-details/?v=1https://www.alamy.de/portrat-einer-glucklichen-dreikopfigen-familie-die-wahrend-des-spaziergangs-im-park-schnee-aus-den-handen-blast-image504756010.htmlRF2M95HCA–Porträt einer glücklichen dreiköpfigen Familie, die während des Spaziergangs im Park Schnee aus den Händen bläst
 Zwei junge Kollegen, die zusammen mit der Sicherheit von Computerprogrammen arbeiten, sitzen mit Computermonitoren am Tisch Stockfotohttps://www.alamy.de/image-license-details/?v=1https://www.alamy.de/zwei-junge-kollegen-die-zusammen-mit-der-sicherheit-von-computerprogrammen-arbeiten-sitzen-mit-computermonitoren-am-tisch-image501950861.html
Zwei junge Kollegen, die zusammen mit der Sicherheit von Computerprogrammen arbeiten, sitzen mit Computermonitoren am Tisch Stockfotohttps://www.alamy.de/image-license-details/?v=1https://www.alamy.de/zwei-junge-kollegen-die-zusammen-mit-der-sicherheit-von-computerprogrammen-arbeiten-sitzen-mit-computermonitoren-am-tisch-image501950861.htmlRF2M4HRCD–Zwei junge Kollegen, die zusammen mit der Sicherheit von Computerprogrammen arbeiten, sitzen mit Computermonitoren am Tisch
 Junger IT-Spezialist, der Programmcodes auf dem Computer schreibt, während er an seinem Arbeitsplatz im IT-Büro sitzt Stockfotohttps://www.alamy.de/image-license-details/?v=1https://www.alamy.de/junger-it-spezialist-der-programmcodes-auf-dem-computer-schreibt-wahrend-er-an-seinem-arbeitsplatz-im-it-buro-sitzt-image501951048.html
Junger IT-Spezialist, der Programmcodes auf dem Computer schreibt, während er an seinem Arbeitsplatz im IT-Büro sitzt Stockfotohttps://www.alamy.de/image-license-details/?v=1https://www.alamy.de/junger-it-spezialist-der-programmcodes-auf-dem-computer-schreibt-wahrend-er-an-seinem-arbeitsplatz-im-it-buro-sitzt-image501951048.htmlRF2M4HRK4–Junger IT-Spezialist, der Programmcodes auf dem Computer schreibt, während er an seinem Arbeitsplatz im IT-Büro sitzt
 Nahaufnahme des Arbeitsplatzes von Entwicklern mit Computern und Laptops auf dem Tisch für Online-Arbeit Stockfotohttps://www.alamy.de/image-license-details/?v=1https://www.alamy.de/nahaufnahme-des-arbeitsplatzes-von-entwicklern-mit-computern-und-laptops-auf-dem-tisch-fur-online-arbeit-image501950523.html
Nahaufnahme des Arbeitsplatzes von Entwicklern mit Computern und Laptops auf dem Tisch für Online-Arbeit Stockfotohttps://www.alamy.de/image-license-details/?v=1https://www.alamy.de/nahaufnahme-des-arbeitsplatzes-von-entwicklern-mit-computern-und-laptops-auf-dem-tisch-fur-online-arbeit-image501950523.htmlRF2M4HR0B–Nahaufnahme des Arbeitsplatzes von Entwicklern mit Computern und Laptops auf dem Tisch für Online-Arbeit
 Junger Programmierer, der Codes auf dem Computer schreibt, um neue Software zu entwickeln, er arbeitet Überstunden im Büro Stockfotohttps://www.alamy.de/image-license-details/?v=1https://www.alamy.de/junger-programmierer-der-codes-auf-dem-computer-schreibt-um-neue-software-zu-entwickeln-er-arbeitet-uberstunden-im-buro-image501951423.html
Junger Programmierer, der Codes auf dem Computer schreibt, um neue Software zu entwickeln, er arbeitet Überstunden im Büro Stockfotohttps://www.alamy.de/image-license-details/?v=1https://www.alamy.de/junger-programmierer-der-codes-auf-dem-computer-schreibt-um-neue-software-zu-entwickeln-er-arbeitet-uberstunden-im-buro-image501951423.htmlRF2M4HT4F–Junger Programmierer, der Codes auf dem Computer schreibt, um neue Software zu entwickeln, er arbeitet Überstunden im Büro
 Gruppe glücklicher Senioren, die auf Stühlen sitzen und mit Psychologen in der Therapie im Pflegeheim arbeiten Stockfotohttps://www.alamy.de/image-license-details/?v=1https://www.alamy.de/gruppe-glucklicher-senioren-die-auf-stuhlen-sitzen-und-mit-psychologen-in-der-therapie-im-pflegeheim-arbeiten-image505977373.html
Gruppe glücklicher Senioren, die auf Stühlen sitzen und mit Psychologen in der Therapie im Pflegeheim arbeiten Stockfotohttps://www.alamy.de/image-license-details/?v=1https://www.alamy.de/gruppe-glucklicher-senioren-die-auf-stuhlen-sitzen-und-mit-psychologen-in-der-therapie-im-pflegeheim-arbeiten-image505977373.htmlRF2MB578D–Gruppe glücklicher Senioren, die auf Stühlen sitzen und mit Psychologen in der Therapie im Pflegeheim arbeiten
 Gruppe von Senioren, die zusammen mit dem Ausbilder auf Stühlen im Pflegeheim trainieren Stockfotohttps://www.alamy.de/image-license-details/?v=1https://www.alamy.de/gruppe-von-senioren-die-zusammen-mit-dem-ausbilder-auf-stuhlen-im-pflegeheim-trainieren-image506957424.html
Gruppe von Senioren, die zusammen mit dem Ausbilder auf Stühlen im Pflegeheim trainieren Stockfotohttps://www.alamy.de/image-license-details/?v=1https://www.alamy.de/gruppe-von-senioren-die-zusammen-mit-dem-ausbilder-auf-stuhlen-im-pflegeheim-trainieren-image506957424.htmlRF2MCNWA8–Gruppe von Senioren, die zusammen mit dem Ausbilder auf Stühlen im Pflegeheim trainieren
 Nahaufnahme eines Psychologen, der während der Sitzung Notizen im Dokument macht Stockfotohttps://www.alamy.de/image-license-details/?v=1https://www.alamy.de/nahaufnahme-eines-psychologen-der-wahrend-der-sitzung-notizen-im-dokument-macht-image505979741.html
Nahaufnahme eines Psychologen, der während der Sitzung Notizen im Dokument macht Stockfotohttps://www.alamy.de/image-license-details/?v=1https://www.alamy.de/nahaufnahme-eines-psychologen-der-wahrend-der-sitzung-notizen-im-dokument-macht-image505979741.htmlRF2MB5A91–Nahaufnahme eines Psychologen, der während der Sitzung Notizen im Dokument macht